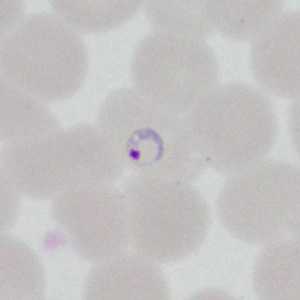
Case377_A

Monthly Case Studies - 2014
December 2014

December - 2014 - Case #385
A 10-year-old girl residing in Pennsylvania was hospitalized with a 101.5º F fever, vomiting, abdominal pain, and diarrhea. The patient had recently returned from visiting family in West Africa.

December- 2014 - Case #386
For the last Monthly Case Study for 2014, the DPDx Team thought we would fill your holiday stockings with a plethora of parasites! The following images were taken from a trichrome-stained stool specimen collected from a Haitian refugee. The original report documented several intestinal protozoa. How many can you identify?
November 2014

November - 2014 - Case #383
A patient presented to a local hospital with encrusted lesions on his arms and legs. A skin scraping was made and examined unstained at 40x magnification.

November - 2014 - Case #384
A 73-year-old woman presented to a local clinic in Ghana with a skin nodule that had developed adjacent to the resection site of a previous low-grade malignant skin tumor.
October 2014

October - 2014 - Case #381
A man was seen as an outpatient at a hospital in Atri, Italy. A stool specimen was collected and processed for ova-and-parasite (O&P) testing. Images of suspect parasites were taken and sent to the DPDx Team for diagnostic assistance.

October - 2014 - Case #382
A 39-year-old immigrant from Panama sought medical evaluation for mild intermittent fevers. A blood specimen was collected and thick and thin blood smears made and stained with Giemsa to confirm a presumed diagnosis of malaria.
September 2014

September - 2014 - Case #379
A 46-year-old woman returned from a trip to Nigeria with multiple boils on her lower back and extremities. Under the care of her primary physician, several fly larvae, one from each boil, were extracted and sent to the state health department for identification.

September - 2014 - Case #380
A 25-year-old male was hospitalized for Crohn’s exacerbation, duodenal outlet obstruction, and regional enteritis. He indicated that he has not had recent travel abroad.
August 2014
August - 2014 - Case #377
A 22-year-old man had a post-travel medical evaluation that included hematologic work-up after returning from an 11-day missionary trip to Honduras. Blood was collected in EDTA at a medical center and thin smears were prepared and stained for examination.

August - 2014 - Case #378
A 25-year-old female presented to a dermatologist with ulcerative lesions on her left arm and both lower legs. She had traveled to Panama three months prior.
July 2014

July - 2014 - Case #375
An 18-year-old female presented a worm-like object to her primary health care provider, claiming it was found in her stool. She spent two months in Mexico five years prior, and admitted seeing similar objects in her stool over the course of the five years.

July - 2014 - Case #376
A state health laboratory received stool specimens collected in in sodium acetate-acetic acid-formalin (SAF) for ova-and-parasite (O&P) examination. The patient was an immigrant, but his specific country of origin was not known.
June 2014

June - 2014 - Case #373
A worm-like object was observed during a routine colonoscopy screening of an adult living in Hawaii. The specimen was collected, sectioned, and stained with hematoxylin-and-eosin (H&E).

June - 2014 - Case #374
A 34-year-old missionary worker sought medical attention for abdominal pain, nausea, and watery diarrhea after returning from visiting friends in Central America.
May 2014

May - 2014 - Case #371
Stool specimens were collected from a 14-year-old refugee from Myanmar as part of a routine screening program. The stool was collected in 10% formalin and zinc PVA (Zn-PVA) and sent to the state health laboratory for ova-and-parasite (O&P) examination.

May - 2014 - Case #372
A 45-year-old patient originally from Mexico presented with a left groin lymphocele, erythema, swelling in his lower extremities, and fever and chills approximately one month after receiving a heart transplant.
April 2014

April - 2014 - Case #369
A 24-year-old male with a history of granulomatous immunodeficiency had biopsy specimens taken of skin lesions on his right forearm.

April - 2014 - Case #370
A 21-year-old female presented with swelling of the eyelid, wrist, and knee. The symptoms started after returning from a three-month trip to Cameroon in 2011.
March 2014

March - 2014 - Case #367
A citizen of the Netherlands presented with abdominal discomfort after returning home from a two-month trip to Suriname. During the second month of his trip, he noticed the appearance of blood and mucus in his stool.

March - 2014 - Case #368
An eight-year-old child presented to a hospital with intermittent fevers. He had recently returned from a trip to Kenya and had not taken anti-malarial prophylaxis while traveling.
February 2014

February - 2014 - Case #365
A 21-year-old immigrant from North Africa had a routine ova-and-parasite (O&P) stool exam performed as part of a refugee screening program.

February - 2014 - Case #366
A 28-year-old male from Algeria had complaints of right upper quadrant (RUQ) abdominal pain. As part of his work up at a medical facility, imaging studies revealed a complex solid and cystic lesion in the posterior right hepatic dome.
January 2014

January - 2014 - Case #363
A 49-year-old female passed a worm-like object approximately three weeks after attending a Thanksgiving potluck for 200 people. Prior to the Thanksgiving meal, the patient had experienced diarrhea for two weeks.

January - 2014 - Case #364
An 81-year-old man, with a previous history of basal-cell carcinoma on his upper right arm and shoulder, presented with a small protuberance in the hollow of his left knee.
DPDx is an education resource designed for health professionals and laboratory scientists. For an overview including prevention and control visit www.cdc.gov/parasites/.
- Page last reviewed: September 2, 2016
- Page last updated: September 2, 2016
- Content source:
- Global Health – Division of Parasitic Diseases and Malaria
- Notice: Linking to a non-federal site does not constitute an endorsement by HHS, CDC or any of its employees of the sponsors or the information and products presented on the site.
- Maintained By:


 ShareCompartir
ShareCompartir